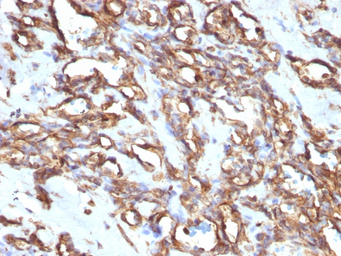
产品细节图片4

相关产品推荐更多 >
万千商家帮你免费找货
0 人在求购买到急需产品
- 详细信息
- 文献和实验
- 技术资料
- 免疫原:
Recombinant full-length human vimentin protein
- 亚型:
IgG1, Kappa
- 形态:
Liquid
- 保存条件:
Store as concentrated solution. Centrifuge briefly prior to opening vial. For short-term storage (1-2 weeks), store at 4℃. For long-term storage, aliquot and store at -20℃ or below. Avoid multiple freeze-thaw cycles.
- 克隆性:
Monoclonal
- 标记物:
Unconjugated
- 适应物种:
Human
- 保质期:
12 months from the shipping date of the product.
- 抗原来源:
Human
- 目录编号:
GTX35163
- 级别:
Primary Antibodies
- 库存:
Available
- 供应商:
GeneTex
- 宿主:
Mouse
- 应用范围:
WB, IHC-P
- 浓度:
0.2 mg/ml(Please refer to the vial label for the specific concentration.)
- 靶点:
Vimentin
- 抗体英文名:
Vimentin antibody [VM1170]
- 抗体名:
Vimentin 抗体 [VM1170]
- 规格:
100 μg

IHC-P analysis of human rhabdomyosarcoma tissue using GTX35163 Vimentin antibody [VM1170].

IHC-P analysis of human melanoma tissue using GTX35163 Vimentin antibody [VM1170].

IHC-P analysis of human Ewing's sarcoma tissue using GTX35163 Vimentin antibody [VM1170].
IHC-P analysis of human angiosarcoma tissue using GTX35163 Vimentin antibody [VM1170].

WB analysis of HepG2 cell lysate using GTX35163 Vimentin antibody [VM1170].

IHC-P analysis of human leiomyosarcoma tissue using GTX35163 Vimentin antibody [VM1170].

IHC-P analysis of human uterus tissue using GTX35163 Vimentin antibody [VM1170].
风险提示:丁香通仅作为第三方平台,为商家信息发布提供平台空间。用户咨询产品时请注意保护个人信息及财产安全,合理判断,谨慎选购商品,商家和用户对交易行为负责。对于医疗器械类产品,请先查证核实企业经营资质和医疗器械产品注册证情况。
 文献和实验
文献和实验secondary antibody review -- data from 99 publications
cytometry used as a control to detect cell responses targeted antigen 7 Alexa Fluor 488 7 Cy3 8 goat IgG Alexa Fluor 488 1:2000 detect antibody binding in human embryonic kidney 293T cells Invitrogen 9 donkey
vimentin (1) NM_003380 346-368 aactacatcgacaaggtgcgc (No silencing observed; 1,2) Human HeLa vimentin (1) NM_003380 1145-1167 aataccaagacctgctcaatg Human HeLa vimentin (1) NM_003380 863-885 aagaatggtacaaatccaagt Human HeLa vimentin (1) NM
抗体片段及其衍生形式 1.双特异性抗体 将两套轻链、重链基因导入骨髓瘤细胞中,选择合适的抗体恒定区及Ig类型,可获得产量大、均一性和高纯度的双特异性抗体。另外,以化学交联技术或杂交―杂交瘤技术也可获得双特异性抗体。 2.Fab抗体 Fab抗体是由重链Fd(即VM+CHl)和完整轻链通过二硫键结合而成的异二聚体,仅含一个抗原结合部位。将重链Fd和完整轻链的编码基因连接,5, 端融合细菌蛋白信号肽基因可在大肠杆菌内分泌型表达
 技术资料
技术资料暂无技术资料 索取技术资料






![MSH3 antibody [N1N2], N-term](https://img1.dxycdn.com/2023/0711/255/2344116916935858761-14.jpg!wh200)
![NF-L antibody [1H3]](https://img1.dxycdn.com/2023/0711/451/6106825198874858761-14.jpg!wh200)

